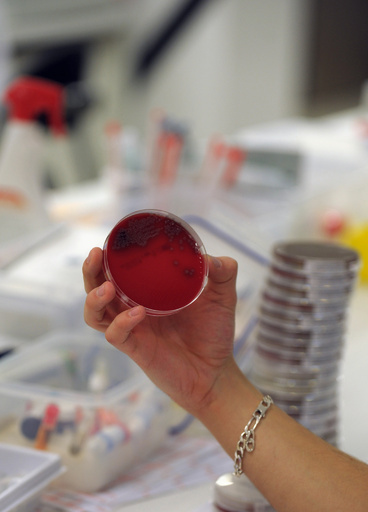
薬剤耐性菌感染、2015年欧州で3万3000人死亡 研究

細菌感染を短時間で判別、抗生物質の過剰処方防止 新機器開発
このニュースをシェア

【5月8日 AFP】患者の検査結果が出るよりも前に医師が強力な抗生物質を処方するという時代は、近く終わりを迎えるかもしれない──。それをもたらすのは、検査結果が数日でなく数十分で判明する最新の機器だ。
この検査機器を開発したのは、米ペンシルベニア州立大学(Pennsylvania State University)の研究チーム。最新機器の詳細を記した論文がこのほど、米科学アカデミー紀要(PNAS)に掲載された。
ウォン・パクキン(Pak Kin Wong)教授(生体工学・機械工学)が共同開発したこの機器は、単一の細菌細胞を捕捉して電子顕微鏡で観察するためにマイクロテクノロジーを利用する。このアプローチを採用することで、細菌の存在や薬物療法に対する感受性をわずか30分ほどで判定できるようになる。結果が出るまでに3~5日かかる既存の臨床検査とは対照的だ。
ウォン教授は、AFPの取材に「現状では、細菌が存在しない場合でも抗生物質が処方されてしまっている」と語り、「これは過剰処方であり、今回の研究によって示そうとしたことの一つだ。細菌感染の存在を迅速に判定することは可能だろうか?」と続けた。
研究論文によると、この機器は細菌の存在を判定できるだけでなく、細胞の形状が球状か、棒状か、らせん状かを判断することで、細菌種の特定に着手できるという。「この機器は細菌の存在を判定するが、それがどのような種類なのかは判定しない」とウォン教授は述べ、「種類の特定を可能にする補完的な分子的アプローチの開発に現在取り組んでいる」と述べた。
細菌の存在が確認されると、その細菌株が耐性を示すかどうかを判断するためにサンプルを抗生物質に暴露する。細菌株が耐性を示した場合には、抗生物質による治療介入は効果がないと考えることができる。
ウォン教授によると、最も一般的な細菌感染症は尿路感染症だという。
「だが、臨床微生物検査室に送られる尿検査サンプルの75%以上は陰性のものだ。細菌が、臨床的に有意義なレベルで速やかに排除または確認されることで、治療は目覚ましく向上するに違いない」
すでに暫定特許を申請済みである研究チームは、病院内や診察室内で使用できるように機器のサイズを縮小化したい考えだ。市場への投入については、3年後との見通しをウォン教授は示している。(c)AFP